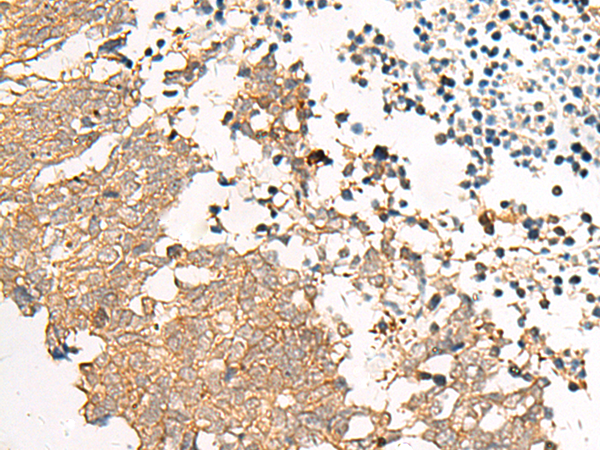
一抗

Background:
This gene is a member of the G-protein coupled receptor 1 family and encodes a multi-pass membrane protein.
Applications:
ELISA, WB, IHC
Name of antibody:
GPR22
Immunogen:
Synthetic peptide of human GPR22
Full name:
G protein-coupled receptor 22
SwissProt:
Q99680
ELISA Recommended dilution:
5000-10000
IHC positive control:
Human cervical cancer and Human lung cancer
IHC Recommend dilution:
40-200
WB Predicted band size:
49 kDa
WB Positive control:
HepG2 cell lysate
WB Recommended dilution:
500-2000



 購物車
購物車 幫助
幫助
 021-54845833/15800441009
021-54845833/15800441009